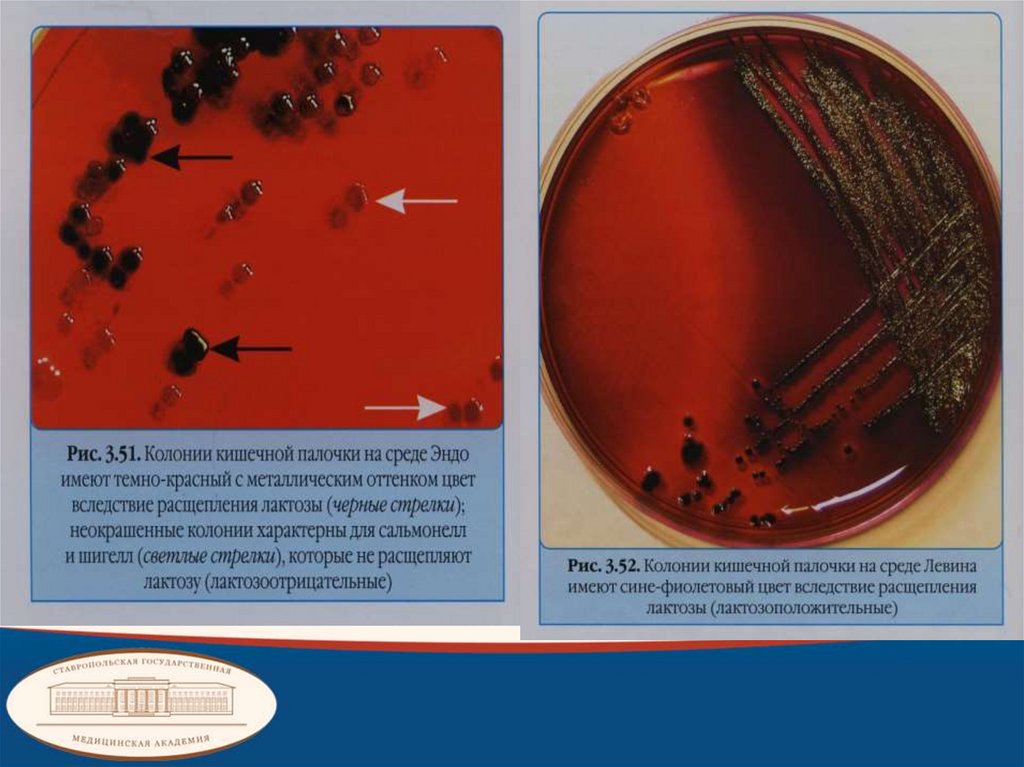
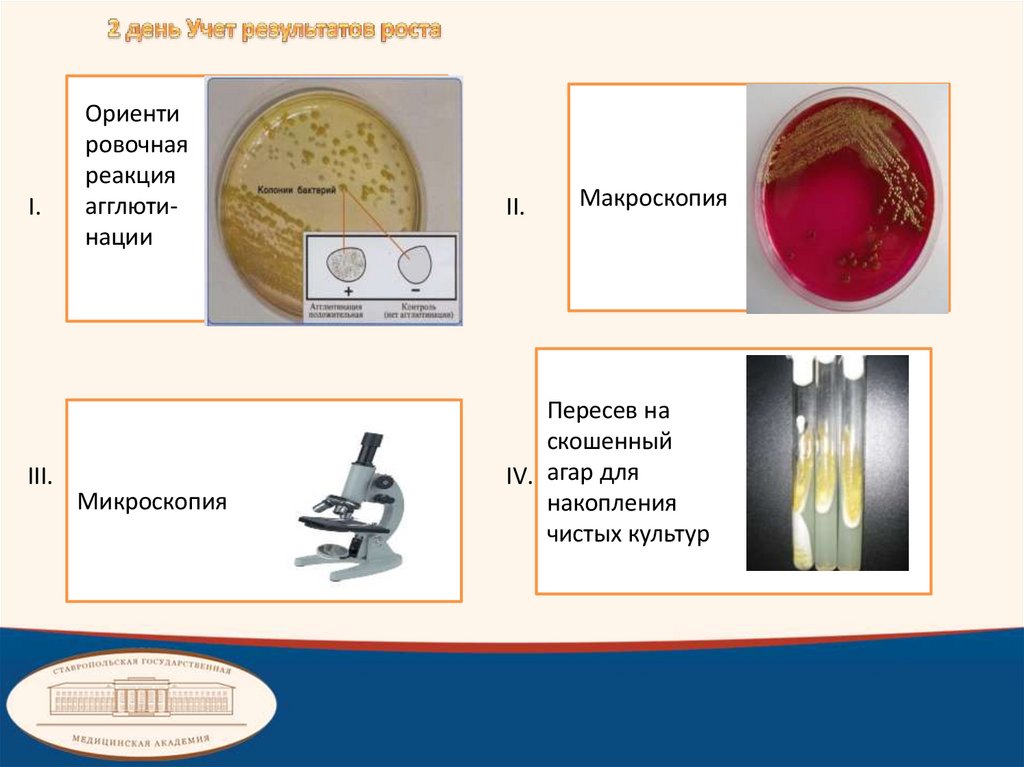

Similar presentations:
Микробиологическая диагностика коли-инфекции
1. Ставропольский государственный медицинский университет
Кафедра микробиологииЗанятие 1
Тема занятия: МИКРОБИОЛОГИЧЕСКАЯ
ДИАГНОСТИКА КОЛИ-ИНФЕКЦИИ
2.
План занятияI. Вопросы для обсуждения
1. Обсуждение теоретических и практических вопросов по теме занятия по
общепринятой схеме.
II. Практическая работа:
1. Самостоятельное изучение демонстрационного материала:
а) морфология кишечной палочки в мазках, окрашенных по Граму;
б) стенд-информация по теме: «Кишечное семейство бактерий»;
2 Коли-инфекции.
3.
БАКТЕРИОЛОГИЧЕСКИЙ МЕТОД:- первый этап: посев исследуемого материала на среду Эндо;
- второй этап: учет результатов роста на среде Эндо, микроскопия подозрительных
колоний;
а) постановка ориентировочной реакции агглютинации с поливалентными ОВ-coli агглютинирующими сыворотками и материалом из колоний;
б) по результатам положительной реакции агглютинации сделать пересев
выбранной колонии на скошенный агар (указать цель этого действия);
в) поливалентные и моновалентные (моноспецифические) ОВ -coli
агглютинирующие сыворотки, получение, использование.
4.
-третий этап: определение чистоты культуры на скошенном агаре;а) микроскопия мазков (окраска по Граму), критерии чистоты культуры.
б) пересев на «пестрый ряд» (указать цель посева);
в) постановка развернутой реакции агглютинации с моноспецифическими ОВ -coli
сыворотками;
-четвертый этап:
а) учет результатов роста на средах «пестрого» ряда,
б) учет развернутой реакции агглютинации;
Вывод: обосновать полученный результат.
3. Санитарно-бактериологическое исследование воды: определение коли-титра
двухфазным бродильным методом.
5.
III. Вопросы для самоподготовки:а) Почему кишечную палочку считают санитарно – показательным микроорганизмом
при санитарном обследовании объектов внешней среды?
б) Что такое коли – титр и коли – индекс?
в) Каково антигенное строение кишечной палочки?
г) Как выделяют чистую культуру диареегенной кишечной палочки?
д) Какой антиген (О или К) определяют в реакции агглютинации с живой культурой?
е) Как обнаруживается О – антиген у кишечной палочки?
ж) По какому антигену окончательно судят о принадлежности бактерий
к патогенному серовару?
6.
з) На какие категории и по каким признакам подразделяют диареегенныекишечные палочки?
и) Какими факторами патогенности обладают энтеротоксигенные кишечные
палочки? Каков генетический контроль их синтеза?
к) Чем обусловлена патогенность энтеротоксигенных кишечных палочек?
л) Чем обусловлена патогенность энтероинвазивных кишечных палочек?
м) С чем связана патогенность энтерогеморрагических кишечных палочек?
н) Каковы основные пути заражения диареегенными кишечными палочками?
о) Можно ли отличить колонии диареегенных кишечных палочек от колоний
непатогенных кишечных палочек на дифференциально — диагностических
средах? Если можно, то в каких случаях?
7.
I.Характеристика возбудителя
1. 1886 г.- открытие кишечной палочки под
названием Bacterium commune,
предположение о ее роли в
происхождении детских
поносов(Эшерих).
2.
Семейство: Enterobacteriaceae
Род: Еsherichia
Вид: E. Coli патогенные
E. Coli условно-патогенные
8.
3. Морфология. E. Coli маленькиеграмотрицательные
факультативно-анаэробные
короткие палочки с
закругленными концами,
размером 2-6*0,4-0,6 мкм,
окрашиваются в красный цвет
Гр(-). В клетке располагаются
беспорядочно или парами, спор
не образуют. У некоторых
штаммов выраженная капсула
или микрокапсула, имеют
жгутики и пили общего типа.
Резистентность. Чувствительны к
дезинфектантам, погибают при 60 С
через 15 минут. Устойчивы в воде и
в почве 3-4 месяца.
9.
Энтеральные эшерихиозы – острые инфекционные заболевания спреимущественным поражением желудочно-кишечного тракта в виде
гастроэнтерита, гастроэнтероколита, вызываемые патогенными
диареегенными штаммами кишечной палочки.
Парентеральные эшерихиозы – острые и хронические гнойные
воспаления в любых органах человека и животного, сопровождающиеся
септицемией вызываемые условно-патогенными штаммами кишечной
палочки самостоятельно или в ассоциации с гноеродными кокками или
другими грамотрицательными бактериями.
E. Coli
ЭПКП
Энтеропато
генные КП
ЭИКП
Энтероин
вазивные
КП
ЭТКП
Энтероток
сигенные
КП
ЭГКП
Энтерогем
орагичес
кие КП
10.
II. Этиология.Культуральные свойства возбудителей
37 С
Наличие О2
рН 7,2-7,5
Питательная
среда –
МПА,среда
Эндо,среда
Левина
Условия
оптимального
роста
Питательная
среда - МПБ
Колонии выпуклые,
мутные, ровные
края (S-форма) или
сухие плоские,
неровные края (Rформа)Диаметр 3-5
мм
Характер роста
Длительность
культивирова
ния-24 ч.
Диффузное
помутнение
бульона и на дне
осадок
11.
12.
Биохимические свойства возбудителейФерментация
Углеводы
Глюкозы
Маннита
Лактозы
До кислоты и газа
Арабинозы
13.
14.
Антигенная структура. E. coliобладает сложной антигенной
структурой. Имеет
соматический О-антиген,
определяющий серогруппу.
Известно около 171
разновидностей этого
антигена.
Поверхностный К-антиген
может быть представлен 3
антигенами: А, В и L,
отличающимися по
чувствительности к
температуре и химическим
веществам.
Типоспецифическим
антигеном является Н-антиген,
определяющий серовары,
которых насчитывается более
57.
15.
Факторы патогенности возбудителей1. Адгезия – прикрепление к эпителиальным клеткам.
2. Колонизация – распространение по поверхности эпителия.
3. Инвазия – проникновение в эпителиальные клетки.
4. Токсины:
a. Эндотоксины( ЛПС-клеточной стенки, выделяется в процессе
разрушения бактерий) определяют форму колоний, антигенную
специфичность бактерий, вызывают развитие эндотоксикозы.
b. Экзотоксины(белок, цитотонины, цитотоксины) стимулируют
выход солей и жидкости в просвете кишечника (диарея),
вызывают разрушение эпителиальных клеток кишечника.
16.
II. Эпидемиология. Источниками инфекции являются больные стертойформы, больные в разгар заболевания, реконвалесцентные,
здоровые бактерионосители. Механизм передачи – фекальнооральный. Факторами передачи являются вода, предметы, молочная
продукция(основной). Пути передачи- водный, контактно-бытовой,
алиментарный(основной). К инфекции наиболее восприимчивы дети
и взрослые.
Иммунитет. Естественно приобретенный – непрочный,
непродолжительный.
Иммунитет
Неспецифический
Специфическая
Пассивный
Бифидум
бактерии
Активный
17.
III. Патогенез.Энтеропатогенные кишечные палочки вызывают колиэнтерит детей раннего
возраста, поражают тонкий кишечник. Происходит адгезия, колонизация,
эшерихии частично внедряются в эпителий в результате чего нарушается
всасывания жидкости (диарея секреторного типа без развития
воспалительных реакций).
Энтероинвазивные кишечные палочки вызывают дизентериеподобные
заболевания детей (взрослые-редко), поражают толстый кишечник.
Происходит адгезия, колонизация, эшерихии полностью внедряются в
эпителий в результате чего возникает воспаление и изъявление слизистой
оболочки (водянистая диарея с примесью крови)
Энтеротоксигенные кишечные палочки вызывают холероподобные
заболевания детей и взрослых, поражают тонкий кишечник. Происходит
адгезия, колонизация, они почти не внедряются в эпителий из-за чего
происходит гиперсекреция жидкости эпителием в результате нарушения
транспорта электролитов (холероподобная диарея)
18.
Энтерогеморрагические кишечные палочки вызывают геморрагическийколит, поражают толстый кишечник. Происходит адгезия, колонизация,
кишечные палочки частично внедряются в эпителий в результате чего
происходит разрушение клеток эндотелия мелких кровеносных сосудов,
поражение кровотока, кровотечение, ишемии и некроз клеточной стенки.
19.
IV. Лабораторные методы диагностикиБактериологический метод
В качестве исследуемого материала используют фекалии, рвотные массы,
промывные воды, кровь
1 день. Посев исследуемого материала на
среду Эндо.
Исследуемый
материал
Посев на среду Эндо
В термостат
при t=37 C
на 24 часа
20.
I.III.
Ориенти
ровочная
реакция
агглютинации
Микроскопия
II.
Макроскопия
Пересев на
скошенный
IV. агар для
накопления
чистых культур
21.
3 день. Учет результата роста. Контроль чистотыкультуры на скошенном агаре.
I.
III.
Макроскопия
Посев смыва чистой
культуры на
пестрый ряд
II. Микроскопия
22.
IV.Развернутая реакция
агглютинации
23.
Серологический метод(вспомогательный)
Для исследования берут
сыворотку крови. Проводят
ИФА. Результаты используют,
главным образом, для
эпиданализа
24.
Изменение цвета в среде ЭндоСостав
среды
Эндо:
МПА + лактоза + основный фуксин(индикатор)

medicine
medicine








